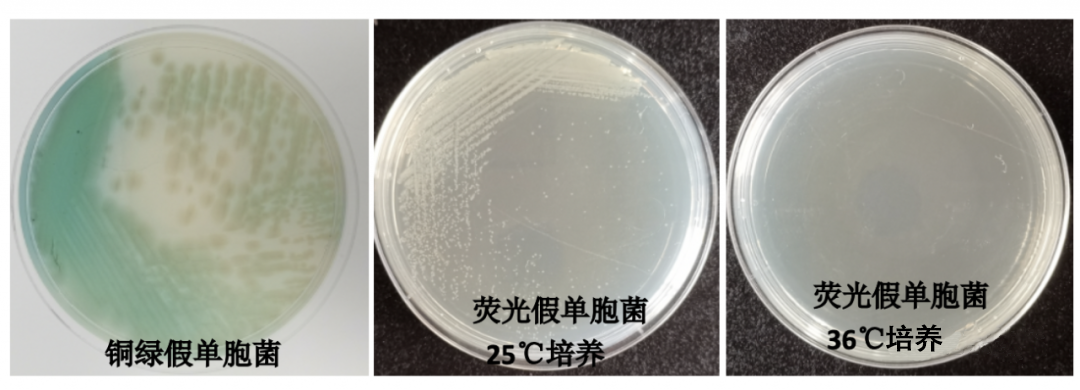
CN琼脂平板上铜绿假单胞菌和荧光假单胞菌的生长特征

用途:用于铜绿假单胞菌的选择性分离培养。
成分(g/L)
|
明胶蛋白胨
|
16.0
|
|
胰蛋白胨
|
10.0
|
|
无水硫酸钾
|
10.0
|
|
无水氯化镁
|
1.4
|
|
溴化十六烷基三甲铵
|
0.2
|
|
萘啶酮酸
|
0.015
|
|
琼脂
|
15.0
|
|
pH值7.1±0.2
|
25℃
|
检验原理:
明胶蛋白胨和胰蛋白胨提供氮源;甘油提供碳源;无水硫酸钾和无水氯化镁可促进绿脓色素的产生;琼脂是培养基的凝固剂;萘啶酮酸抑制非假单胞菌的革兰氏阴性杆菌。
用法:
秤取本品50.6g,另取甘油10ml,加热溶解于1000ml蒸馏水中,分装,121℃高压灭菌15分钟,备用。
注:甘油需用户自备。
注:培养基中含少量氯化镁,灭菌后可能出现微量沉淀。
CN琼脂平板上铜绿假单胞菌和荧光假单胞菌的生长特征:
铜绿假单胞菌,36℃培养生长良好,为蓝绿色菌落;
荧光假单胞菌在CN琼脂上36℃生长较弱,25℃生长良好,且为淡黄色菌落

365nm紫外灯下观察荧光反应,荧光假单胞菌荧光明显
与CFC选择性培养基的区别:
1.从成份上:两者相同,不同的是他们选择的抑菌剂不同,即添加剂的成份不同。
2.从作用上:假单胞cfc选择性培养基是用来推荐分离假单胞菌属,比如分离洋葱假单胞菌,它的质控菌是:目标菌选择洋葱假单胞菌,非目标菌选择的是金葡菌。CN琼脂是推荐分离铜绿假单胞菌(又称绿脓假单胞菌或绿脓杆菌),它的质控菌是,目标菌为铜绿假单胞菌,非目标菌是变形杆菌,水中及有水的环境中广泛存在的铜绿假单胞菌。
假单胞菌琼脂基础培养基/CN琼脂微生物灵敏度试验:
按标签用法制备培养基,接种以下质控菌株,放置36±1℃需氧培养24-48小时。

相关资料:
假单胞菌琼脂基础培养基的原理及现象 点击查看


 海博微信公众号
海博微信公众号
 海博天猫旗舰店
海博天猫旗舰店


 海博微信公众号
海博微信公众号
 海博天猫旗舰店
海博天猫旗舰店






